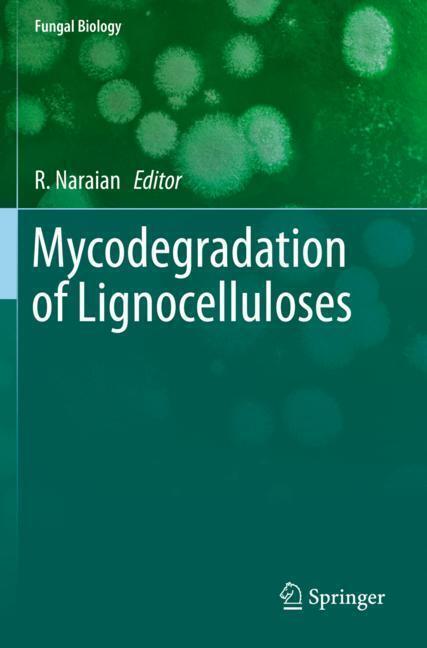

Laboratory Protocols in Fungal Biology
Mycology has an integral role to play in the development of the biotechnology and biomedical sectors. It has become a subject of increasing importance as new fungi and their associated biomolecules are identified. As this discipline comes to the forefront of research in these sectors, the requirement for a consolidation of available research approaches is required. The First Edition of this book has a few basic and applied protocols. With the Second Edition, this book provides consolidated information on recent developments and the most widely used mycological methods available in the fields of biochemistry, biotechnology and microbiology. The methods outlined offer clear and concise directions to the reader and covers both standard protocols and more applied mycological methods. This book provides useful information for undergraduates, post-graduates, and specialists and researchers studying fungal biology.
Preface
Long Term Preservation of Fungal Cultures in All-Russian Collection of Microorganisms (VKM): Protocols and ResultsConfocal Laser and Epifluorescence Microscopy
Diagnose of Chytid Parasites of Algae in The Plankton
Sabouraud Agar for Fungal Growth
FISH, Fluorescence in Situ Hybridization of Uncultured Zoosporic Fungi
Real-time Quantitative PCR Assay for Counting Uncultured Zoosporic Fungi
Real-Time PCR Assay in Fungi
Rapid Identification and Detection of Pathogenic Fungi by Padlock Probes
Extraction and Characterization of Taxol: An Anticancer Drug from an Endophytic And Pathogenic Fungi
Recent Advances in Applications of Machine Learning in Fungal Biology
Fungal Conservation
TBD
Loop-Mediated Isothermal Amplification of the Entomopathogenic Fungi, Beauveria bassiana
Molecular Taxonomy and Multi-Gene Phylogeny of Fungi
Yeast Isolation Methods from Specialized Habitats
Assays for the Quantification of Antioxidant Enzymes in Fungi
Index.
| ISBN | 978-3-030-83748-8 |
|---|---|
| Medientyp | Buch |
| Auflage | 2. Aufl. |
| Copyrightjahr | 2022 |
| Verlag | Springer, Berlin |
| Umfang | VI, 261 Seiten |
| Abbildungen | VI, 261 p. 24 illus., 15 illus. in color. |
| Sprache | Englisch |